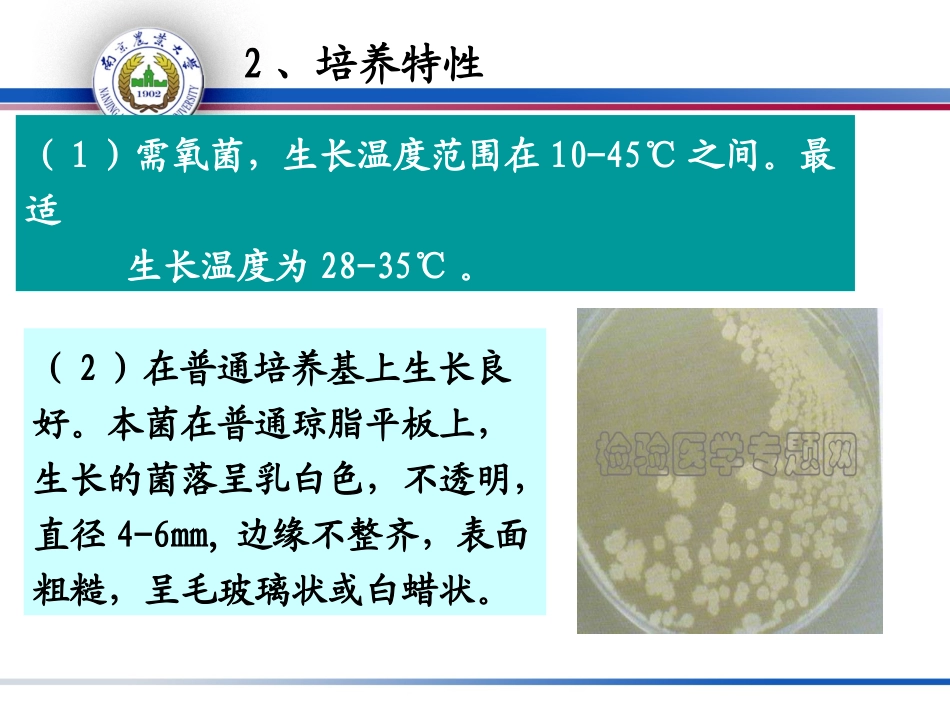

蜡样芽胞杆菌(Bacilluscereus)的检验(一)蜡样芽胞杆菌生物学性状1、形态和染色特性该菌为革兰氏阳性的大杆菌,菌体两端较平整,芽胞呈椭圆形,位于菌体中央稍偏一端,多呈链状排列,无荚膜,有周鞭毛
2、培养特性(1)需氧菌,生长温度范围在10-45℃之间
最适生长温度为28-35℃
(2)在普通培养基上生长良好
本菌在普通琼脂平板上,生长的菌落呈乳白色,不透明,直径4-6mm,边缘不整齐,表面粗糙,呈毛玻璃状或白蜡状
(3)在血液琼脂平板上形成浅灰色、不透明、似毛玻璃状的菌落
菌落周围初呈草绿色溶血,时间稍长即完全透明
(4)蜡状芽胞杆菌在甘露醇卵黄多粘菌素琼脂(MYP)上的菌落为粉红色(表示不发酵甘露醇),周围有粉红色的晕(表示产生卵磷脂酶)
(5)在普通肉汤内生长迅速,肉汤混浊,常常有菌膜或壁环,振摇易乳化
3、生化性状:(1)葡萄糖发酵试验:接种于酚红葡萄糖肉汤中,厌氧条件下35℃培养24h
培养基应由红色变为黄色
(2)硝酸盐还原试验:阳性(红色)
(表明本菌在厌氧条件下分解葡萄糖产酸)(3)V-P试验:接种于改良V-P培养基中,35℃培养48h
加V-P试剂及肌酸数粒,静止1h,应为阳性反应(伊红色)
(4)L-酪氨酸分解试验:接种于L-酪氨酸琼脂培养基上,35℃培养48h,阳性反应菌落周围培养基应出现澄清透明区(表示产生酪蛋白酶)
阴性时应继续培养72h再观察
(5)溶菌酶试验:用直径2mm接种环取纯菌悬液一环,接种于溶菌酶肉汤中,35℃培养24h
该菌在本培养基(含0
001%的溶菌酶)中能生长
如出现阴性反应,应继续培养24h
4、致病性蜡样芽胞杆菌引起食物中毒,除必须具有大量的细菌外,肠毒素也是重要的致病因素
耐热性肠毒素:100℃30分钟不能被破坏,为引起呕吐型中毒的致病因素,常在米饭中形成
不耐热肠毒素:是引起腹泻型胃肠炎的病因,能在各种食物